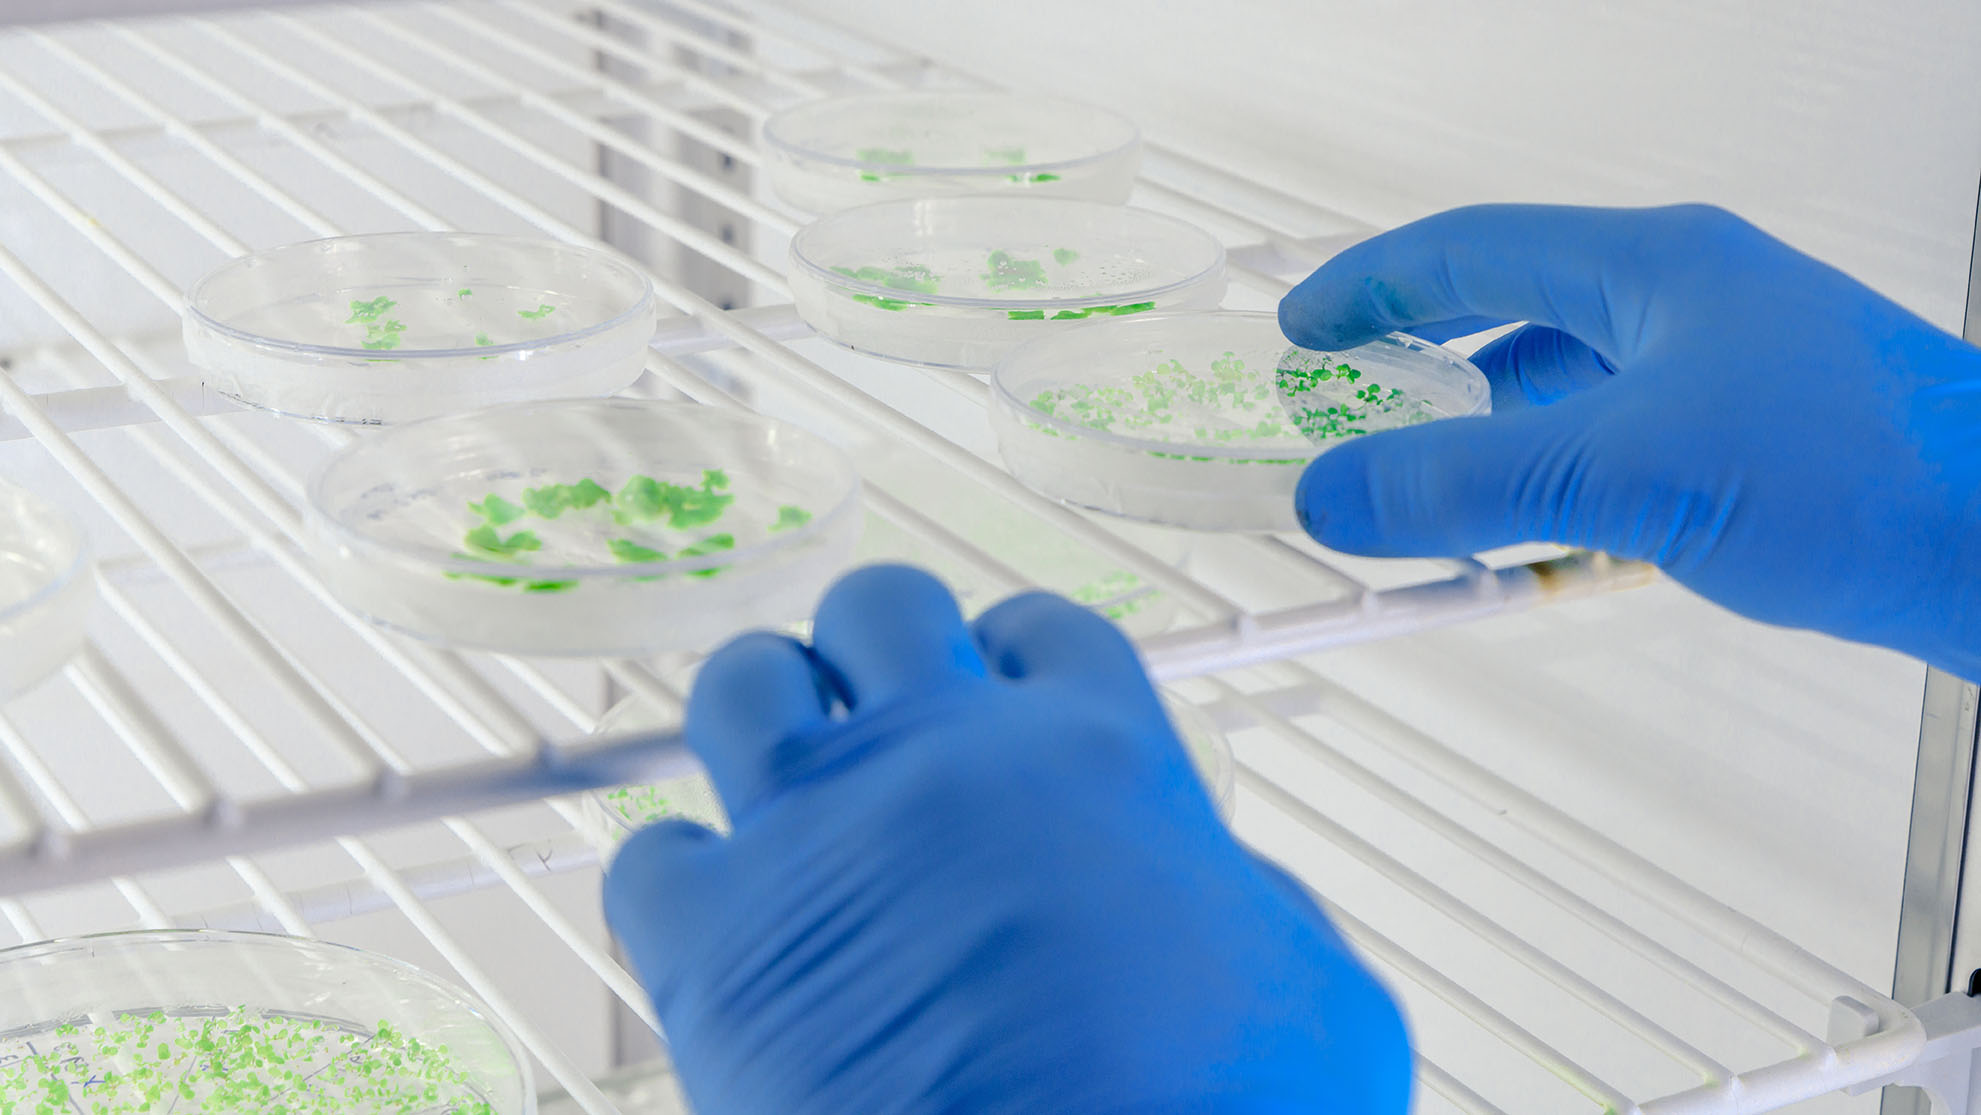

Para conocer las herramientas de desarrollo de matrices de gestión de riesgos.
Incluye templates.
Para aprender lo importante y lo que no me puede faltar en mis depósitos.
Para adquirir tips sobre gestión eficiente y eficaz de auditorías, tanto a proveedores, como internas.
Para saber con qué herramienta conviene trabajar en situaciones diversas.
Incluye templates.
Para llevar adelante validaciones y protocolos.
Incluye templates.